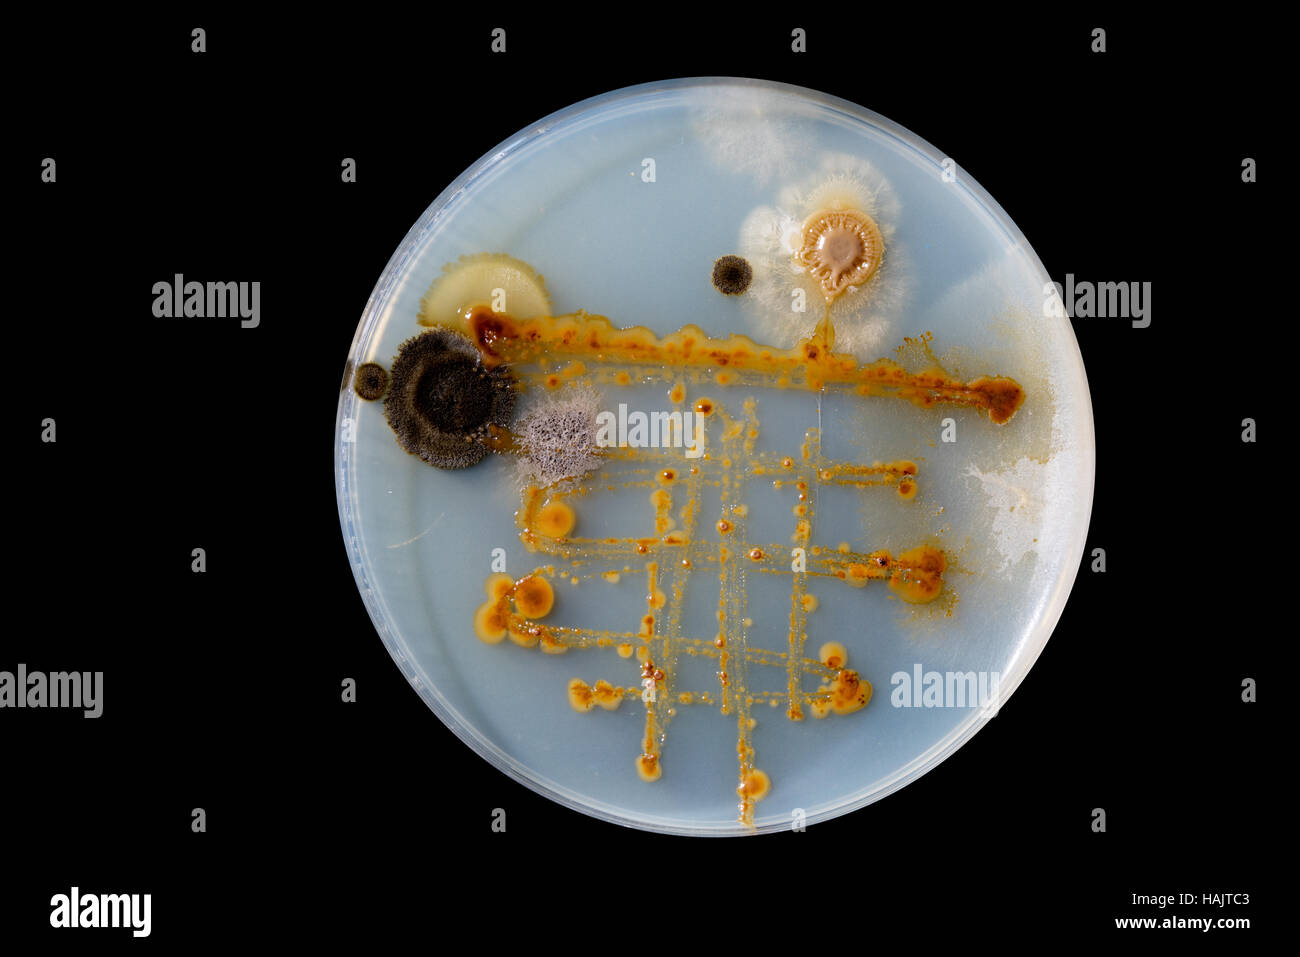
Micro organisms Fotos und Bildmaterial in hoher Auflösung Alamy

Microcreagrinae es una subfamilia de pseudoscorpiones de la familia Neobisiidae.
Géneros
Según Pseudoscorpions of the World 1.2::[1]
- Acanthocreagris Mahnert, 1974
- Alabamocreagris Ćurčić, 1984
- Americocreagris Ćurčić, 1982
- Australinocreagris Ćurčić, 1984
- Bisetocreagris Ćurčić, 1983
- Cryptocreagris Ćurčić, 1984
- Dentocreagris Dashdamirov, 1997
- Fissilicreagris Ćurčić, 1984
- Globocreagris Ćurčić, 1984
- Halobisium Chamberlin, 1930
- Insulocreagris Ćurčić, 1987
- Lissocreagris Ćurčić, 1981
- Microcreagris Balzan, 1892
- Minicreagris Ćurčić, 1989
- Orientocreagris Ćurčić, 1985
- Roncocreagris Mahnert, 1974
- Saetigerocreagris Ćurčić, 1984
- Stenohya Beier, 1967
- Tartarocreagris Ćurčić, 1984
- Tuberocreagris Ćurčić, 1978
Referencias
Enlaces externos
- Wikimedia Commons alberga una categoría multimedia sobre Microcreagrinae.
- Wikispecies tiene un artículo sobre Microcreagrinae.
- En ION
- Nomenclator Zoologicus